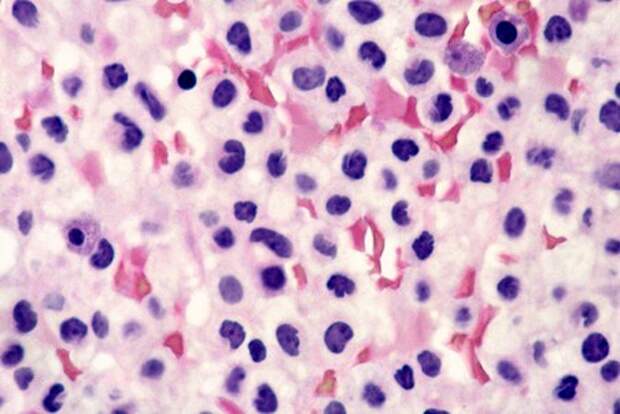

Главный тренер итальянской "Болоньи" Синиша Михайлович рассказал о состоянии своего здоровья, передает Football Italia.
50-летний наставник болен лейкемией - раком крови.
"Да, я провел ночь в слезах. И хотя у меня еще остались слезы, но они не от страха. Я уверен, что выиграю в этой битве", - заявил Михайлович.
Ранее сообщалось, что в семье главного тренера мадридского "Реала" Зинедина Зидана произошла трагедия .
Свежие комментарии